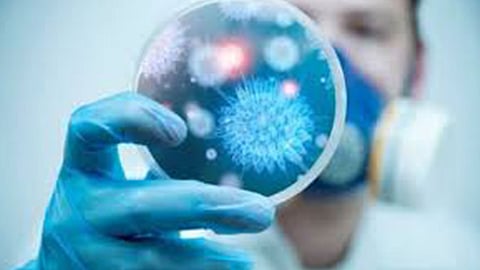

ارتفع عدد الإصابات بفيروس كورونا المستجد في لبنان إلى 28 إصابة بعد إعلان مستشفى رفيق الحريري الجامعي المخصص لعلاج واستقبال المصابين,في تقريره اليومي عن آخر المستجدات حول الفيروس,عن تسجيل ست إصابات جديدة.
وأعلن مستشفى رفيق الحريري الجامعي,في تقريره اليوم السبت,أنه «أجريت فحوصات مخبرية لـ140 حالة,جاءت نتيجة 134 منها سلبية,وست حالات إيجابية».
وأضاف: «بلغ عدد الحالات التي شُخِّصت بإصابتها بفيروس كورونا المستجد داخل الأراضي اللبنانية,28 إصابة».
وأشار التقرير إلى أن «وضع المصابين بفيروس كورونا المستجد,مستقر ما عدا ثلاث حالات وضعهم حرج,وجميعهم يتلقون العناية اللازمة في وحدة العزل».
وكانت أولى الإصابات بفيروس كورونا في لبنان كشف عنها في 21 فبراير الماضي,وهي سيدة كانت آتية على متن طائرة من مدينة قم في إيران. ويشهد مطار رفيق الحريري في بيروت إجراءات استثنائية للوقاية من الأمراض,بتركيب 22 جهازًا حديثًا على جميع الممرات المتحركة والسلالم الكهربائية في المطار,لتعقيمها تلقائيًّا وبوتيرة دائمة».
اقرأ أيضًا: